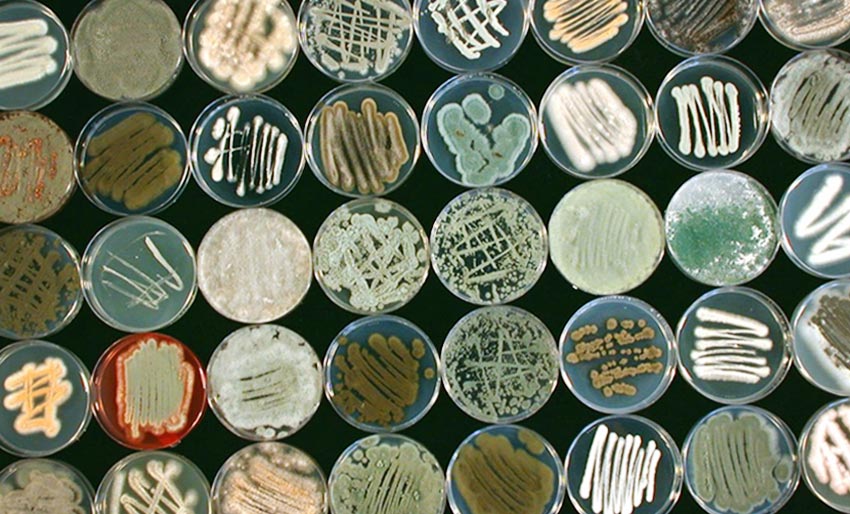
Sopp i havet er en skattkiste

Sopp i havet er en skattkiste
Tirsdag 9. september 2025
Hele veien fra fjæra til dyphavet finnes det en undervurdert skattkiste av liv og biologisk mangfold som vi knapt har begynt å undersøke. Denne skattkista er marin sopp.
Til nå er det beskrevet rundt 2.000 arter av sopp i havet, og masterstudent Simen Karoliussen er blant dem som forsker på feltet.
– Marin sopp har et stort potensial for menneskeheten. Vi må bare skaffe mer kunnskap om hvilke sopper vi har og hvordan vi kan bruke dem, skriver han på Forskersonen.no.
– Marin sopp har et stort potensial for menneskeheten. Vi må bare skaffe mer kunnskap om hvilke sopper vi har og hvordan vi kan bruke dem, skriver han på Forskersonen.no.
Annonse: